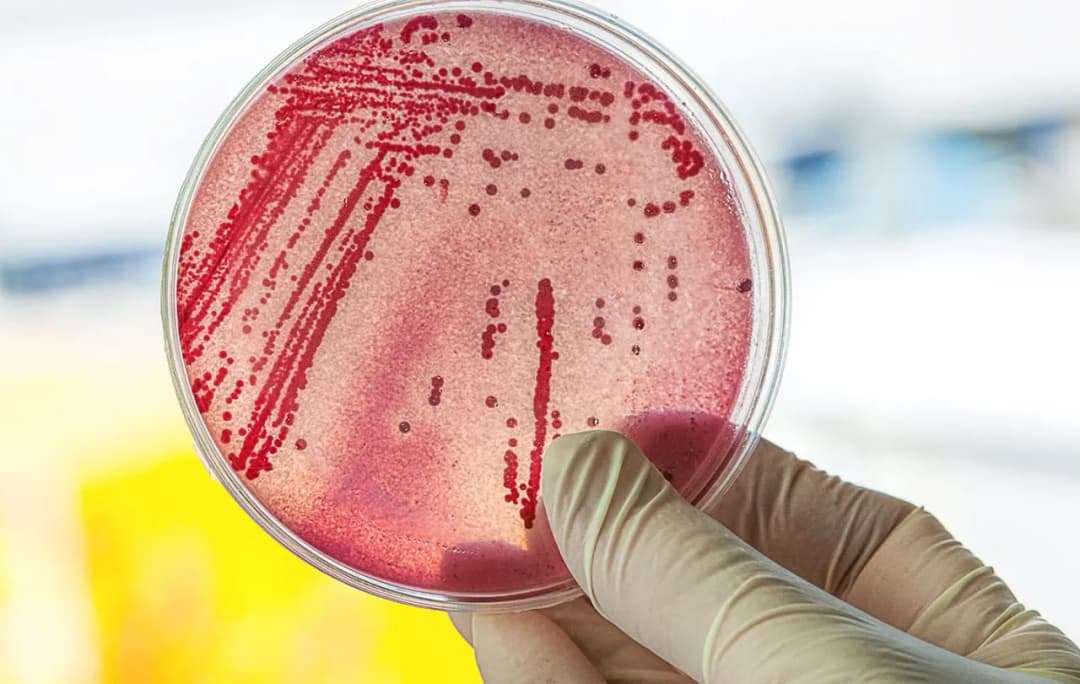
Symptome E. coli: Erkennen Sie die gefährlichen Anzeichen einer Infektion

Erleben Sie die Vorteile des Garnier Vitamin C Serums für strahlende Haut. Entdecken Sie die besten Produkte und Tipps zur Anwendung für optimale Ergebnisse.

Erleben Sie die Vorteile des Garnier Vitamin C Serums für strahlende Haut. Entdecken Sie die besten Produkte und Tipps zur Anwendung für optimale Ergebnisse.

Erfahren Sie die wichtigsten Unterschiede zwischen einem Privatrezept und einem Kassenrezept, um die beste Wahl für Ihre Medikamente zu treffen.

Erfahren Sie alles über die besten Medikamente gegen Blasenentzündung. Linderung und Heilung durch gezielte Behandlungen für Ihre Gesundheit.

Erfahren Sie alles zur Ulcus duodeni Diagnostik. Entdecken Sie wichtige Methoden zur Früherkennung von Geschwüren und deren Bedeutung für die Behandlung.
Erfahren Sie alles über die Symptome E. coli und erkennen Sie die gefährlichen Anzeichen einer Infektion, um schnell zu handeln und Ihre Gesundheit zu schützen.

Erfahren Sie, wie Sie mit effektiven Erkältung Medikamenten Symptome lindern können. Entdecken Sie die besten Optionen und vermeiden Sie Risiken für Ihre Gesundheit.

Erfahren Sie die entscheidenden Unterschiede zwischen Kassenrezept und Privatrezept sowie die Kostenfallen, die Patienten beachten sollten.

Erfahren Sie alles über die Diagnose des Flush-Syndroms, einschließlich wichtiger Symptome, Tests und präventiver Maßnahmen zur Linderung der Beschwerden.

Erfahren Sie mehr über die typischen Bronchitis Symptome bei Frauen und welche Warnzeichen Sie nicht ignorieren sollten, um ernsthafte Komplikationen zu vermeiden.

Erfahren Sie alles über b Vitamin 12: wichtige Quellen, Symptome eines Mangels und die gesundheitlichen Vorteile für Ihr Wohlbefinden.